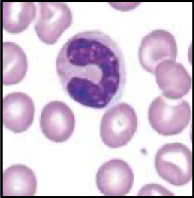
term image
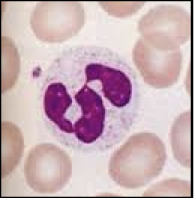
term image
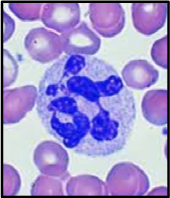
term image
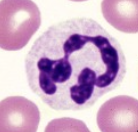
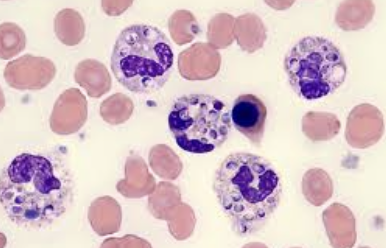
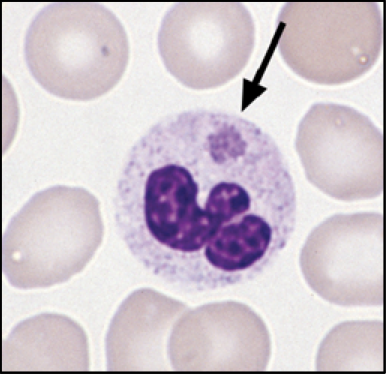
<p>what disease is affecting these and what is it</p>
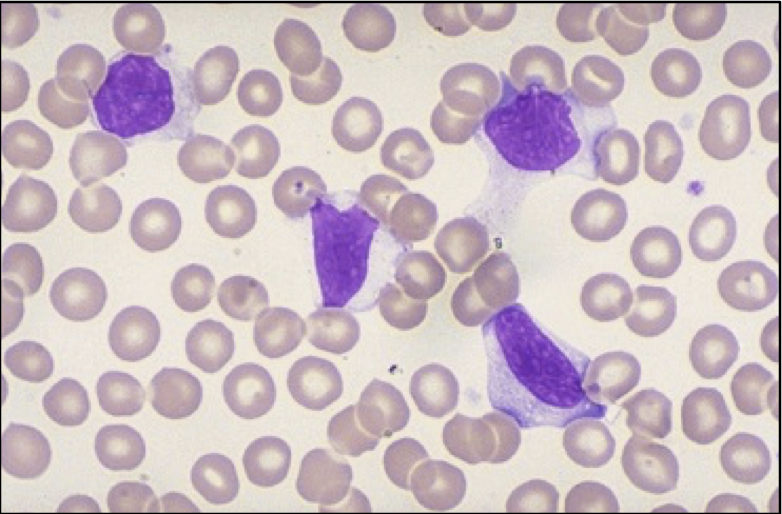
term image
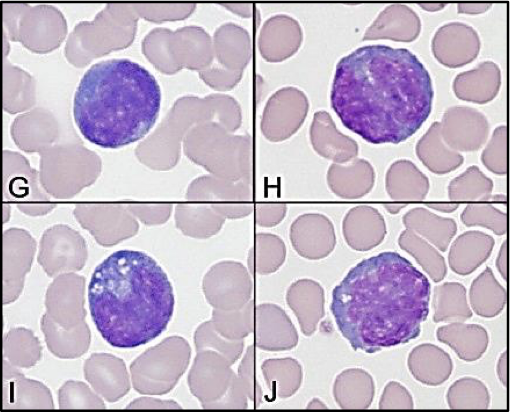
term image
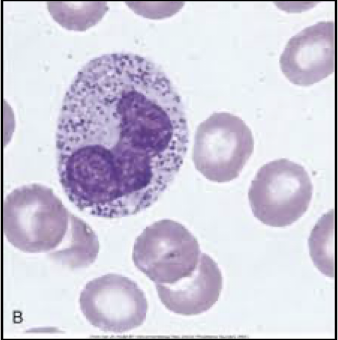
term image
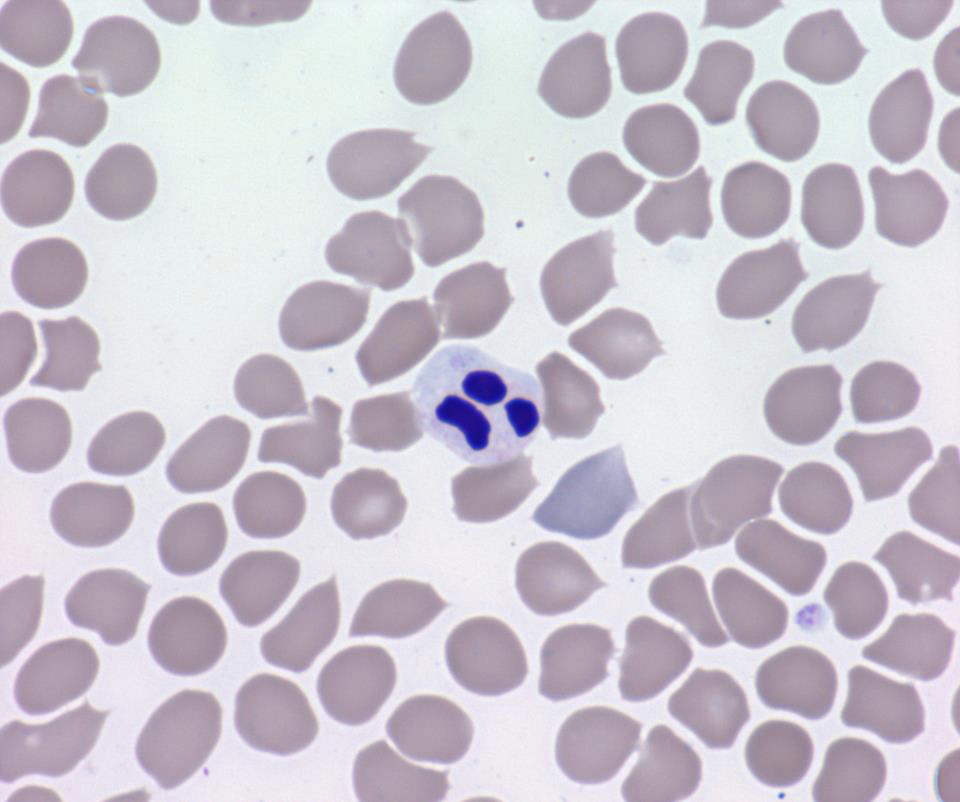
<p></p>
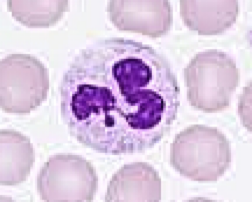
<p>what is that dot at the bottom what is it found in</p>
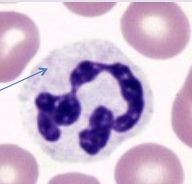
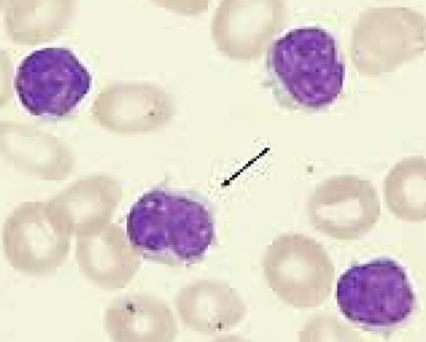
<p>what is it, what is arrow pointing at</p>
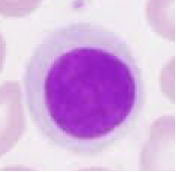
term image
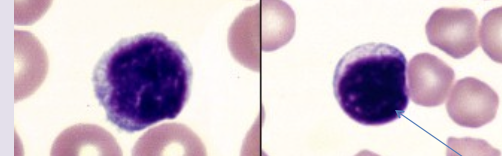
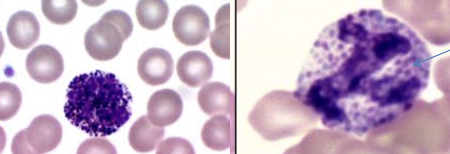
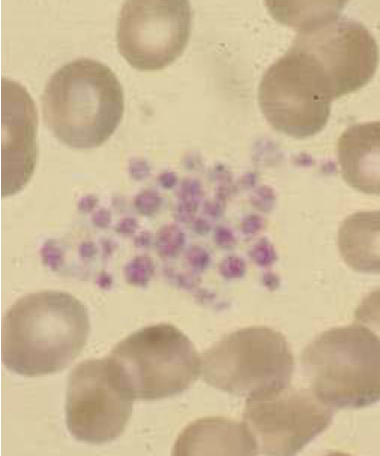
<p>what is this called</p>
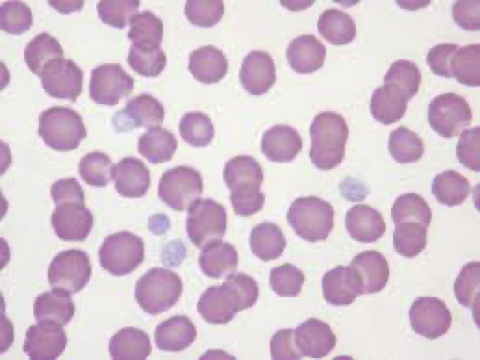
<p>purple things</p>
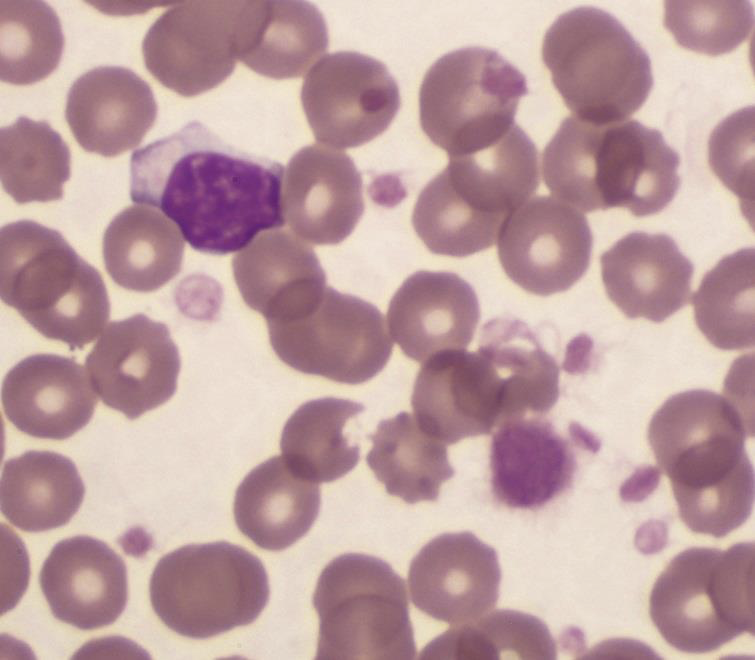
<p>what is the bottom purple thing</p>
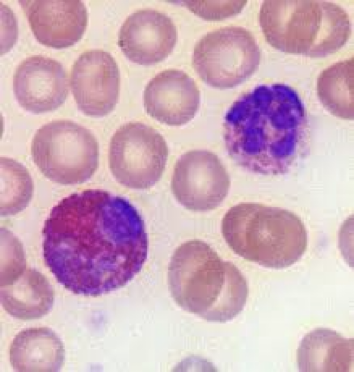
term image
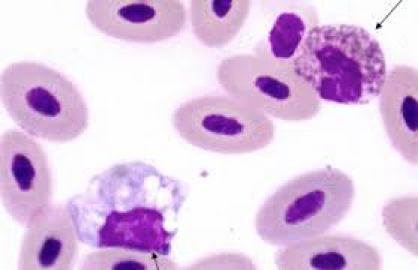
<p>what species </p>

1/112
Looks like no tags are added yet.
Name | Mastery | Learn | Test | Matching | Spaced |
|---|
No study sessions yet.

Myeloblast

Promeylocyte and Myelocyte

Metamyelocyte
What types of immature neutrophils should not be seen in circulating blood stream
Myeloblast, Promeylocyte, Myelocyte
What do you do if we see a myeloblast, promeylocyte or myelocyte in circulating blood stream?
Count them as separate cells in differential, and call to vet’s attention
band- neutrophil
Segmented Neutrophil
How should you record band cells
Recorded as separate cells
Hyper-segmented Neutrophil
what type of neutrophil is normal
Segmented Neutrophil

Toxic neutrophil, Dohle bodies

Toxic neutrophil, Small basophilic granules

what is this and what are arrows pointing to
Toxic neutrophils
top arrow-cytoplasmic basophilia
left arrow- cytoplasmic vacuolation
right arrow- dohle bodies

Band neutrophil
Neutrophil

Toxic neutrophil
what disease is affecting these and what is it
Neutrophil, Histoplasma

what disease is affecting these and what is it
Neutrophil, Distemper

what disease is affecting these and what is it
Neutrophil, Ehrlichia or Anaplasma phagocytophilium
what disease is affecting these and what is it
Neutrophil, Ehrlichia or Anaplasma phagocytophilium
Atypical Lymphocytes
How to explain what a atypical lymphocyte looks like
Cytoplasm gets pulled out into ‘wonky” shapes when making slides

Reactive lymphocytes

what is it and what is it pointing to
atypical lymphocyte, Azurophilic granules (small reddish purple granules)

reactive lymphocyte

reactive lymphocyte
reactive lymphocyte
explan what a reactive lymphocyte looks like
larger
more cytoplasm
bluer cytoplasm
lacier chromatin
vacuoles
abnormal monocytes

abnormal monocytes
why do we get abnormal monocytes
EDTA tends to distort monocytes see irregular margins and more vacuoles
when do we see Pyknotic neutrophils and monocytes
early stage of apoptosis- programmed cell death
Pyknotic neutrophil

Pyknotic neutrophil

Pyknotic Monocyte

Plasma, Buffy coat, RBC’s
What is PCV
proportion (%) of blood composed of red blood cells
PCV potential errors
not mixing sample before filling tube
including the buffy coat in PCV value
Too much anticoagulant dilutes blood
centrifuge error- not enough rpms
plasma is made up of how much proteins (%)
5-10%
what proteins are in plasma
Albumin
globulins
fibrinogen
Potential errors in TP value
Glass shards-use unbroken end of tube
plasma cloudiness-hemolysis or lipemia
refractometer scratches or being dirty
what tube do we use for blood smears
purple top EDTA

lipemic sample

yellow one
icteric sample

left one
hemolyzed sample

name zones from left to right
body, monolayer, feathered edge
what do cells look like in body
cells piled on top of each other
not appropriate for differentials
what do cells look like in monolayer
cells are laying in single later close but not touching
appropriate area for differentials and estimates
what does feathered edge look like
cells are very far apart with large gaps
not appropriate for differentials
order of stains used for staining slides
methyl alcohol- fixer
Eosinate stain- reds
Methylene blue stain- purples
how many dips in each stain for staining slides
10
what is average total blood volume in all animals
8%
what is a safe amount of total blood volume we can remove from a healthy adult. why would we do this
20%, for blood transfusion donation
how much total blood volume is in each animals body weight.
hot blooded horses
cats,ruminants, lab animals, cold blooded horses
dogs
pigs
10-11% Body Weight – Hot-blooded horses
▪ 6-7% Body Weight - cats, ruminants, lab animals, cold-
blooded horses
▪ 8-9% Body Weight -dogs
▪ 5-6% Body Weight - pigs
what to do with microscope setting for differntials
light?
WBC’s estimate
platelets estimate
condenser up and light source bright
40x for WBC objective lens
100x for platelet objective lens
how to calculate WBC estimate
count WBC in 10 feilds (40x)
divide by 10
x by 2,000
how to calculate platelet estimate
count all in 10 fields (100x)
divide by 10
x 20,000
how to get absolute WBCs
total WBC estimate X % of each WBC found on differential
ex: 40 neutrophils (0.4) X WBC estimate
what is a WBC absolute most useful for
evaluating health/disease
what is used on 100x
everything but WBC estimate
how much bigger are neutrophils than RBC
2-2.5 bigger than RBC
what is that dot at the bottom what is it found in
barr body, females (neutrophils)
why may neutrophils show up pink to red
too many dips in solution
what to look for in neutrophils
small granules
segmented nucleus
occasional band
what spceies
neutrophil-canine

what species
neutrophil, cat

what species
neutrophil, equine

what species
Neutrophil, bovine
how much bigger are lymphocytes then RBC’s in dogs and cats
1-1.5
how much bigger are lymphocytes then RBC’s in livestock
2-2.5
what is it, what is arrow pointing at
lymphocyte, scant cytoplasm
lymphocyte

lymphocyte
what animal is this in and what is it
dog,cat lymphocyte

what animal is this in and what is it
equine, bovine lymphocyte
what do monocytes look like
nucleus often seems frothy with dark spots and irregular shapes
big
often have vacuoles
small granules
how much bigger is a monocyte than a RBC
4-4.5

monocyte

monocyte

what animal is this in and what is it
canine, feline monocyte

what animal is this in and what is it
equine, bovine monocyte

Eosinophil
what does a eosinophil look like
large pink granules
segmented nucleus
a big larger than neautrophil

what animal is this in and what is it
canine, feline eosinophil

what animal is this in and what is it
Equine, bovine Eosinophil

what is this
mast cells- from cutaneous tumor in dog
what does a basophil look like
Dark blue granules
segmented nucleus
a bit larger than neutrophil
what animal is this in and what is it
canine, feline basophil

what animal is this in and what is it
equine, bovine basophil

basophil
what is this called
platelet clump
purple things
platelets

right to left
RBC, platelet, WBC
what is the bottom purple thing
giant plateletes

Heterophil
heterophil

what species
heterophil, rabbit
what species
heterophil, reptiles and birds

heterophil